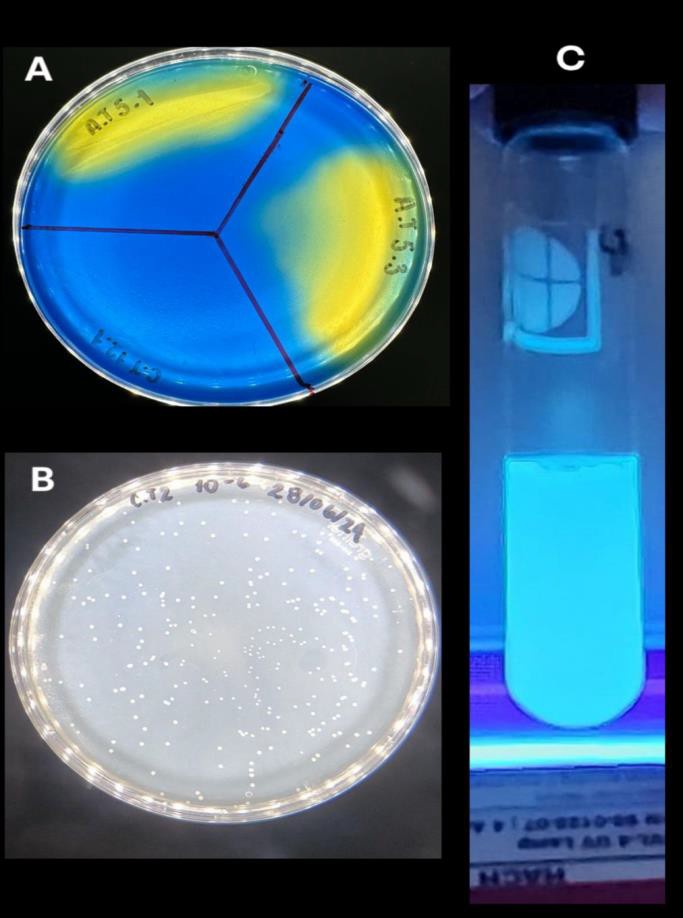

PROSPECCIÓN BIOTECNOLÓGICA CON POTENCIAL AGRÍCOLA DE MUESTRAS AMBIENTALES
Mario Rietti-Osorio¹, Andrés S. Ortiz-Morazán¹, ²
¹Escuela de Microbiología, Facultad de Ciencias, Universidad Nacional Autónoma de Honduras, Tegucigalpa, Honduras
²Instituto de Investigación de Microbiología
Autor de correspondencia: aortizm@unah.edu.hn
INTRODUCCIÓN
En la actualidad, la utilización de agroquímicos ha generado un impacto en el medioambiente, transformando la agricultura en una actividad de alto costo. El uso de microorganismos con la capacidad de fijar y solubilizar nutrientes [1,2], así como la producción de fitohormonas que promuevan la germinación y estimulen el crecimiento vegetativo de las plantas, podría reducir los costos de producción, mejorando las condiciones de vida de los productores y su seguridad alimentaria.
METODOLOGÍA
Se recolectaron muestras ambientales provenientes de parques nacionales y reservas forestales (Figura 1) en condiciones estériles. Luego, se realizaron diluciones seriadas y se sembraron por la técnica de extendido en superficie en agar Ashby para determinar su potencial fijador de nitrógeno [3]. Posteriormente, las colonias características fueron sembradas en agar Aleksandrov para comprobar su potencial solubilizador de nutrientes [4]. Estas cepas fueron caracterizadas bioquímicamente mediante metodologías convencionales y el sistema API. Se realizó la extracción de ADN mediante el método de CTAB y su amplificación con cebadores específicos para estos microorganismos [5].
RESULTADOS
Se recolectaron un total de 57 muestras, de las cuales se aislaron 44 cepas con características relacionadas con la fijación de nitrógeno atmosférico. De estas, 11 presentaron características solubilizadoras de nutrientes como potasio y sodio, lo que podría indicar la presencia de géneros como Azotobacter y Azospirillum, microorganismos comúnmente descritos para estos fines [6]. Por otro lado, se observó que tres de las cepas poseen la capacidad de producir fluorescencia, indicando la posible presencia de Pseudomonas fluorescens [7].

Figura 1. Localización de los sitios de muestreo. El indicador rojo muestra la localización del Parque Nacional Montaña del Celaque, el indicador amarillo presenta la localización del Parque Nacional Cerro Azul Meambar (PANACAM), el localizador verde el Parque Arqueológico Copan Ruinas y el localizador violetas indica la localización del parque Aguas termales Luna Jaguar, Aguas termales Presidente y Aguas termales Aguaca
Figura 2. Imagen A). Colonias bacterianas en agar Aleksandrov. Imagen B) Colonias bacterianas en agar Ashby. Imagen C) Fluorescencia observada en cultivo bacterianos en Caldo Nutritivo
CONCLUSIÓN
Las muestras provenientes de zonas de reserva poseen un alto potencial para el aislamiento de microorganismos con fines agrícolas. Estas cepas mostraron capacidad tanto para la fijación y solubilización de nutrientes como para la producción de fitohormonas estimulantes de la germinación. Se recomienda continuar con estudios similares en otras zonas de reserva [8].
REFERENCIAS
1. Orhon D, Sekoulov I, Dulkadiroglu H. Innovative technologies for wastewater treatment in coastal tourist areas. Water Sci Technol. 2002;46(8):67–74.
2. Massoud MA, Tarhini A, Nasr JA. Decentralized approaches to wastewater treatment and management. New York: Springer; 2009.
3. Rodríguez L. El tratamiento descentralizado de aguas residuales domésticas. En: Pérez G, editor. Saneamiento sostenible en Latinoamérica. Ciudad de México: UNAM; 2015. p. 29–35.
4. Organización Mundial de la Salud. Calidad del agua y saneamiento. 2022 [citado 10 Mar 2025]. Disponible en: https://www.who.int
5. Sood Y, Singhmar R, Singh V, Malik DK. Isolation and Characterization of Potential Potassium Solubilizing Bacteria with Various Plant Growth Promoting Traits. Biosci Biotechnol Res Asia. 2023;20(1):79–84.
6. Sun S, Chen Y, Cheng J, Li Q, Zhang Z, Lan Z. Isolation, characterization, genomic sequencing, and GFP-marked insertional mutagenesis of a high-performance nitrogen-fixing bacterium, Kosakonia radicincitans GXGL-4A and visualization of bacterial colonization on cucumber roots. Folia Microbiol (Praha). 2018;63(6):789–802.
7. Álvarez-García JA, Santoyo G, Del M, Rocha-Granados C. Pseudomonas fluorescens: Mecanismos y aplicaciones en la agricultura sustentable. Revista Latinoamericana de Recursos Naturales. 2020;16(1):01–10.
8. Velasco-Jiménez A, Castellanos-Hernández O, Acevedo-Hernández G, Aarland RC, Rodríguez-Sahagún A. Bacterias rizosféricas con beneficios potenciales en la agricultura. Terra Latinoamericana. 2020;38(02):333–45.
Cómo citar este trabajo (Vancouver):
Rietti-Osorio M, Ortiz-Morazán AS. PROSPECCIÓN BIOTECNOLÓGICA CON POTENCIAL AGRÍCOLA DE MUESTRAS AMBIENTALES [resumen]. En: Vispo NS, editor. Memorias del Congreso de Investigación y Posgrado UNAH 2024: Libro de resúmenes. Madrid/Tegucigalpa: Clinical Biotec S.L.; Universidad Nacional Autónoma de Honduras; 2024. doi: 10.70099/cb/unah/2024.mem
ISBN del libro: 978-84-09-76685-7